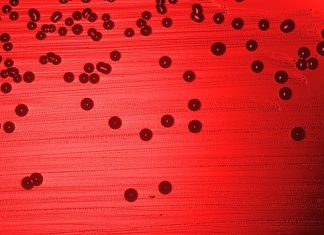
Experimental rapid test developed to diagnose bacterial sinusitis Experimental rapid test developed to diagnose bacterial sinusitis

Neurobiological basis discovered for human relationships with dogs
Brain chemistry and function as observed with functional magnetic resonance imaging have revealed the similarities and differences in how the human brain responds to...
Study predicts higher rates of obesity based on ‘healthy’ food costs
The cost of healthy food has risen faster than the cost of unhealthy food in the United Kingdom. Nicholas R. V. Jones and colleagues...
Experimental rapid test developed to diagnose bacterial sinusitis
Science Daily reported today that researchers out of The Ohio State University Wexner Medical Center and Nationwide Children's Hospital have developed a rapid screening...
Myasthenia gravis associated with psychiatric symptoms
A recent study suggests that a disproportionately high number of those with myasthenia gravis suffer from psychiatric complications. This is especially the case when...
Scleroderma may cause psychiatric symptoms, studies suggest
A recent study conducted on psychiatric problems associated with sclerodoma suggest that those afflicted with the condition are unusually predisposed to psychiatric problems. In...
New study gives the cerebellum its rightful place in human evolution
The cerebellum should be given more credit for the evolutionary developments in human ancestors and man than it has previously been given. This is...
Immune dysfunction in mother may be linked with autism, say researchers
A recent, large-scale study showed that in about 10 percent of mothers, there are antibodies in their bloodstream that react with the proteins in...
Psoriasis and pemphigus may cause psychiatric problems, say researchers
Several studies suggest that there is a high comorbidity of psychiatric complications with pemphigus. In one study, the prevalence of psychiatric problems among the...
UCLA breakthrough for colon cancer and ulcerative colitis
Researchers at UCLA’s Jonsson Comprehensive Cancer Center have discovered a revolutionary experimental therapy, which has the ability to suppress the development of ulcerative colitis...
Common spice reported to effectively treat head and neck cancer
Since antiquity, plant products have been used to treat diseases. In fact, a number of currently available prescription medications such as digitalis and quinine...